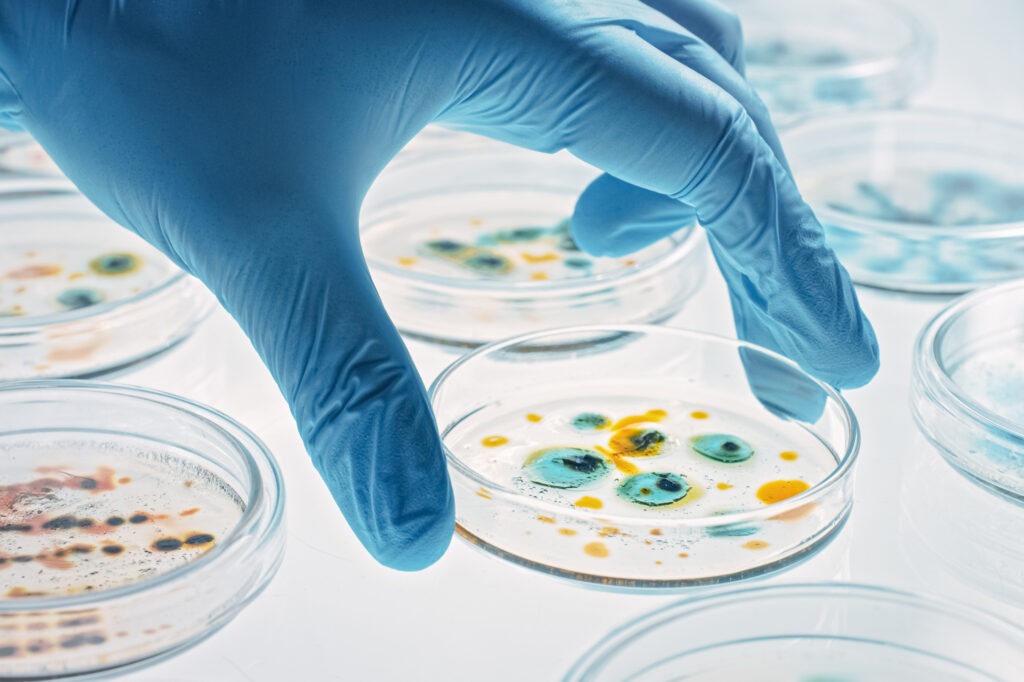
Лабораторный эксперимент с бактериями

Производство топлива из воздуха и воды, материалы со суперспособностями и солнечные панели, которые умеют залечивать повреждения. Эти технологии либо уже существуют, либо находятся в активной разработке, и если получится их внедрить, они помогут традиционной энергетике покрыть ежегодно растущие потребности в энергии. Ассоциация «Глобальная энергия» выпустила ежегодный доклад «Десять прорывных идей в энергетике на следующие десять лет», где собрала перспективные открытия ученых. «Энергия+» рассказывает о том, как они устроены.
Оксид церия для солнечных реакторов
Идея получать синтетическое топливо из воды и воздуха с помощью солнечного света обсуждается не первый год. Речь идет о так называемых солнечных реакторах, где за счет концентрированного солнечного излучения можно производить синтез-газ и водород — без использования других источников энергии.Важную роль в этом процессе играет оксид церия. Его нагревают мощным потоком солнечного света, из-за чего материал теряет часть кислорода. Затем химическое соединение вступает в реакцию с водой и углекислым газом, образуя синтез-газ — сырье для производства топлива, например метанола.
У этого решения есть серьезные ограничения: солнечные реакторы отличаются невысоким КПД, а производство оксида церия остается дорогим. Однако если эти проблемы удастся решить, получение топлива буквально из воздуха превратится из научной экзотики в реальную технологию.

Умные микрокапсулы для нефтедобычи
Это крошечные полые контейнеры диаметром от тысячи до одного микрометра. Для сравнения: хорошо знакомая по урокам биологии инфузория-туфелька достигает в длину около 130–150 микрометров. Внутри микрокапсул находятся химические вещества и соединения, умными их называют потому, что их можно заранее программировать: в зависимости от задачи менять размеры и форму, состав ядра и оболочки, а также управлять их поведением в различных средах.
Эта технология может быть особенно ценной в нефтедобыче — например, для укрепления скважин, их ремонта и изоляции, а также для увеличения притока нефти. В отличие от растворов и других химических соединений капсулы можно доставить до места назначения и там разрушить ультразвуком или микроволновым излучением, высвободив содержащийся внутри реагент. Такое точечное воздействие делает все процедуры точнее и экономичнее.
Микробное масло для производства авиатоплива
Ученые — в том числе российские — научились производить экологичное топливо для судов и самолетов из кулинарных масел. Один из возможных следующих шагов — замена растительного масла на так называемое микробное. Его вырабатывают колонии особых микроорганизмов — бактерий, плесени, дрожжей и водорослей. В качестве сырья используются бросовые продукты — от отработанной патоки до сырого глицина и отходов производства древесины. Как показали исследования, микробное масло действительно может служить сырьем для получения авиационного топлива, соответствующего международным стандартам. Только чтобы поставить эту технологию на поток, нужно решить несколько непростых задач: в частности, найти способ увеличить выход масла из микробных колоний и разработать новые катализаторы для его более эффективной переработки.
Максены — материал будущего
Максены — это очень тонкие материалы, состоящие из чередующихся слоев металла и углерода. За счет своей структуры они обладают целым рядом выдающихся свойств — от гибкости до высокой электропроводности, а также обеспечивают возможность тонкой настройки в зависимости от конкретных задач. В разных ситуациях это синтетическое вещество может обладать противоположными свойствами: например, впитывать влагу или, наоборот, отталкивать ее.
Потенциальная сфера применения такого материала будущего включает десятки самых разных областей — в том числе производство мощных суперконденсаторов, солнечных батарей, электрохимических сенсоров, а также опреснение морской воды и даже изготовление новых типов покрытий для самолетов-невидимок.
Биоинспирированные материалы
Идею материалов, способных самостоятельно восстанавливаться после повреждений, ученые подсмотрели в живой природе — отсюда и название «биоинспирированные», то есть вдохновленные биологическими организмами.
Такие материалы особенно востребованы в удаленных и замкнутых энергосистемах, где ремонт и замена оборудования затруднены. Например, самовосстанавливающиеся солнечные панели могут «залечивать» повреждения от влаги и пыли, а нефте- и газопроводы из «умных» полимеров — устранять трещины и царапины, возникшие во время эксплуатации.

Солнечные панели на территории Омского нефтеперерабатывающего завода
Инновации газовой промышленности
В газовой отрасли уже сегодня используются технологии, которые позволяют заметно повысить эффективность работы энергетических систем. К таким прорывным решениям относятся, например, современные агрегаты для перекачки газа с КПД выше 35%, способные безотказно работать более 100 тысяч часов, в том числе установки «Ладога», выпускаемые на Невском заводе в Санкт-Петербурге.
В числе других направлений — трубы большого диаметра с гладкой внутренней поверхностью, снижающей энергозатраты при сжатии газа, и транспортировка голубого топлива под большим давлением, позволяющая значительно сэкономить на энергопотреблении.
Гибридные суперконденсаторы
Это новый класс систем накопления энергии, объединяющий свойства аккумуляторов и суперконденсаторов. От первых они берут способность накапливать большие объемы энергии, от вторых — быстро отдавать ее короткими импульсами и выдерживать множество циклов зарядки и разрядки. Такой принцип «два в одном» делает гибридные суперконденсаторы универсальными и открывает для них широкий круг применения — от электромобилей и космической техники до медицины и бытовой электроники.
Экономные энергосистемы
Еще одно направление связано с сокращением потерь электроэнергии при ее передаче по сетям. Для этого разрабатываются усовершенствованные провода с композитными сердечниками, которые почти не нагреваются при высоких нагрузках, а также новые трансформаторы и «умные» линии электропередачи. Такие сети способны учитывать погоду и текущую нагрузку и автоматически подстраивать режим работы. По оценкам экспертов «Глобальной энергии», внедрение этих решений может снизить потери электроэнергии в сетях примерно с 6 до 3%.

Расчет для «ядерной батарейки»
Специалисты Боливийского агентства по атомной энергии предложили собственный подход к оценке целесообразности внедрения в тех или иных регионах «ядерных батареек»: малых модульных реакторов — компактных, легких в обслуживании и способных обеспечивать энергией даже самые удаленные территории.
Методика учитывает ключевые факторы — от состояния инфраструктуры до доступности электроэнергии для населения — и позволяет заранее понять, какие задачи может решить такая установка и есть ли в регионе условия для ее эффективной работы.
Энергетические сообщества
Не совсем технология, но смелый концепт: идея умных городов, жители которых могут самостоятельно производить энергию (например, при помощи ветряков или солнечных панелей) и обмениваться ею. Такая система взаимовыручки могла бы позволить оптимизировать нагрузку на государственные электрические сети, повысить их эффективность и долговечность.


























